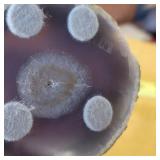

View current listings by this company
(11-13) Amazing ONLINE COLLECTIBLE AUCTION. WW2, Hummel, Hudson. Ends Sat 6. Sunday pick up
Listing ID#: 450972
| Sale Location |
|---|
|
Fresno, CA 93720 |
| Sale Dates and Times |
|---|
|
Bidding Starts: Sunday Oct 31, 9:00 AM Bidding Ends: Saturday Nov 13, 6:00 PM |
| Sale Type |
|---|
 Online Auction (local pick-up only)
VIEW ONLINE CATALOG Online Auction (local pick-up only)
VIEW ONLINE CATALOG |

| Company Information |
|---|
|
Leftover Treasures Contact: Phillip Sifuentes Phone: 559-499-9722 Email: phillip.sifuentes@gmail.com Website: leftovertreasures.com EstateSale.com ID#: 4324 View company information and listings |
Free Email Notifications
Sign up for the EstateSale.com email notifications and we will let you know about sales in your area! You may set up alerts by area (zip and radius), keywords, and by company. It is FREE and only takes a few seconds to sign up.
| Listing Terms and Conditions |
|---|
|
To participate you must visit and register on www.leftovertreasures.com
|
| Listing Video |
|---|
| Listing Information |
|---|
|
IMPORTANT INFO
Please Read! NO ITEMS WILL BE BROUGHT TO 5161 N. BLACKSTONE WAREHOUSE!!!!!
New Accounts / Bidder Registration: If you need assistance creating an online account. We can make one for you: Over the phone or during Open House/Preview Hours.
In Person Preview Hours: By Appointment Only- Call 559-691-6100 to schedule.
Soft Closing / Bidding
Pick Up Instructions.
Questions? Call/Text 559-691-6100 10am to 6pm. Pick up address: 575 E. Braddock | Fresno, Ca
Sale Terms and Conditions
CLICK HERE TO VIEW AUCTION ITEMS |
|
Photo Gallery
|
|||||
|---|---|---|---|---|---|
|
|||||